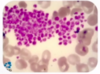

3 séries do hemograma
Eritrograma, leucograma e plaquetograma
Valor de referência: eritrócitos
- Eritrócitos; 3.9 - 5.0 milhões
- Nº de hemácias por ml
Hb VR
- M: 12-15 g/dL
- H: 13-16,5 g/dL
- Quantidade de hb dentro da hemácia
Ht VR
- Ht: 36-46%
- Volume da massa eritróide
- Ht = VCM x E
VCM VR
- 80-100 fL
- Volume médio dos eritrócitos
- VCM = Ht/E
HCM VR
- 27-32 pg
- Hemoglobina corpuscular média
- HCM = Hb/E
CHCM VR
- 31-36 g/dL
- Concentração hemoglobínica corpuscular média
- CHCM = HCM/VCM
RDW VR
- 12-25%
- Variação do tamanho das hemácias
A eritropoese (formação dos eritrócitos) inicia-se na medula óssea com o precursor eritrocítico (= _ )
Proeritroblasto

A eritropoese dura em torno de _ dias e a hemácia dura cerca de _ dias
7 dias; 120 dias

Eritrócitos que acabaram de perder o núcleo, duram cerca de 40h até virarem hemácias, são maiores e ainda possuem restos de núcleo são…
Reticulócitos
Anemia hiperproliferativa: quantidade de reticulócitos e principais representantes
RETICULÓCITOS AUMENTADOS > 2% ou > 100 mil: anemias hemolíticas ou sangramentos
Anemia hipoproliferativa: quantidade de reticulócitos e principais representantes
RETICULÓCITOS NORMAL OU REDUZIDOS: carenciais (Fe, B12, AF), deficiência EPO, distúrbios medulares
Quando e como devemos corrigir o valor dos reticulócitos
Quando há anemia e o valor for dado em %

Anemia microcítica
VCM < 80 fl
Anemia hipocrômica
HCM < 27
VR plaquetas
150-450.000
Macrocitose: VCM?
VCM > 100 fL
Macrocitose: pensar em?


- A) Anemia hipoproliferativa, macrocítica, normocrômica com anisiocitose (RDW)
- B) (parece se tratar de megaloblástica) Hábitos alimentares, reposição de vitaminas e sintomas gastrointestinais (perniciosa = principal causa)
Leucócitos VR
4.000-10.000/mm3

Até o estágio de bastonete as células do leucograma são _ e um desvio delas é chamado de …

Reação leucemóide X leucemia mielóide crônica

Pergunta que deve ser feita na plaquetopenia